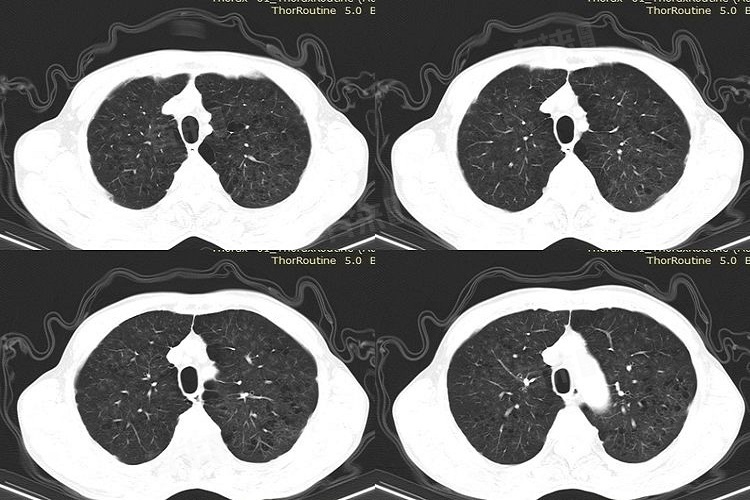

肺部CT片子的阅读对于非医学专业人员来说可能较为复杂,但掌握一些基本要点可以帮助初步了解片子上的信息。
1、区分片子的正反面
- 片子通常包含患者的姓名、性别、检查日期等基本信息,这些信息多位于片子的右上角或左上角。可以通过患者姓名的拼音顺序来辨别片子的正反面,确保正确解读。
2、了解片子的构成
- 肺部CT片子通常包括肺窗和纵隔窗两种图像,肺窗主要显示肺部的结构和病变。纵隔窗主要用于观察纵隔内的软组织、血管、淋巴结等。
3、观察肺窗图像
- 注意肺纹理是否清晰,气管、支气管的走行是否正常。观察肺内是否有异常的密度影,如磨玻璃影、结节影等,这些可能是炎症、肿瘤等病变的表现。留意是否存在气胸、肺不张等病变情况。
4、分析纵隔窗图像
- 观察纵隔内是否有明显的肿大淋巴结,这可能与肿瘤、感染等疾病有关。检查纵隔内是否有占位性病变,如胸腺瘤、淋巴瘤等。注意食管是否有增厚,以及有无胸腔积液、肋骨骨折、胸壁异常等情况。
5、结合临床病史和症状
- 在阅读CT片子时,应结合患者的临床病史和症状进行综合分析。例如,患者是否有咳嗽、咳痰、发热等症状,这些症状可能与片子上的病变表现相关联。
肺部CT片子的解读需要较高的专业知识和经验,因此如果片子上有异常表现或自己无法确定的情况,应及时咨询专业医生或影像科医师的意见。非医学专业人员不要自行诊断病情,而应及时就医并遵循医生的建议。
如果肺ct片子发现异常,应该怎么办
- 立即将CT检查结果交给专业医生进行解读和评估。医生会根据异常的具体情况和患者的病史、症状等信息,给出进一步的诊断和治疗建议。
- 向医生询问异常的具体性质,例如是炎症、结节、肿块还是其他类型的病变。了解异常的大小、位置、形态等详细信息,以便对病情有更全面的认识。
- 根据医生的建议,可能需要进行进一步的检查,如血液检查、病理活检、增强CT等,以明确诊断。如果需要治疗,应严格按照医生的指导进行,包括药物治疗、手术治疗、放疗、化疗等。
- 在治疗期间,注意保持良好的生活习惯,如戒烟、限酒、合理饮食、适量运动等。避免接触有害物质,如二手烟、空气污染等,以减少对肺部的刺激和损伤。

